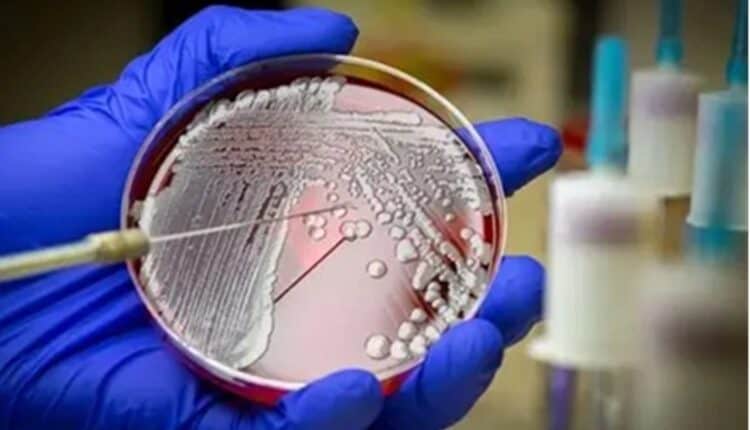

NUS Medicine to get S$2 mn grant to boost infectious disease diagnostics across Asia
The programme, DETECT-Asia (Strengthening Diagnostics for sEvere bacTErial infeCTions in Asia), is a regional initiative which will enhance microbiology testing for severe bacterial infections across Asia, contributing to the global fight against AMR
The Yong Loo Lin School of Medicine, National University of Singapore (NUS Medicine) will get a co-funded gift of S$2 million from the Novo Nordisk Foundation and Temasek Foundation to support a programme to enhance the diagnostics for severe bacterial infections and combat antimicrobial resistance (AMR), a deadly health issue in Asia.
The programme, DETECT-Asia (Strengthening Diagnostics for sEvere bacTErial infeCTions in Asia), is a regional initiative which will enhance microbiology testing for severe bacterial infections across Asia, contributing to the global fight against AMR. AMR remains a major health challenge, responsible for an estimated 4.7 million deaths globally in 2021, with Asia bearing a particularly high burden, driven by challenges such as limited diagnostic infrastructure, gaps in systematic surveillance, and uneven access to quality healthcare. Estimates by the World Economic Forum also indicate that strengthening solutions across the Asia-Pacific region could generate annual healthcare savings of $10–15 billion while reducing socio-economic loss by $35–40 billion.
Led by the ADVANCE-ID (ADVANcing Clinical Evidence in Infectious Diseases) team—a clinical research network based at NUS involving over 100 hospitals in Asia, the programme aims to:
• Enhance the speed and accuracy of diagnostics for severe bacterial infections, including those associated with high mortality and AMR, such as bloodstream infections and hospital-acquired pneumonia;
• Strengthen diagnostic infrastructure in hospitals across Asia, helping to improve clinical decision-making and treatment outcomes;
• Contribute to regional efforts to address AMR by enabling more timely identification of resistant pathogens and supporting data-driven approaches to care; and
• Lay the foundation for future large-scale interventional studies, and support the development of standardised protocols, workforce training, and regional data and material sharing practices that can be scaled over time.
Adjunct Assistant Professor Mo Yin, Deputy Director, ADVANCE-ID, NUS, said, “Severe multidrug resistant infections remain a major cause of death and illness across Asia, driving socio-economic inequity. DETECT-Asia marks a crucial step toward better diagnostics and more effective patient care. With the support of the Novo Nordisk Foundation and Temasek Foundation, we are well-positioned to further enhance the regional capacity, data, and collaborations needed to strengthen pandemic resilience and transform infectious disease management in Asia.” Adj Asst Prof Mo Yin is also from the Infectious Diseases Translational Research Programme at NUS Medicine.
Dr Marianne Holm, Vice President, Infectious Diseases, Novo Nordisk Foundation, said, “Antimicrobial resistance is one of the most pressing global health challenges, with disproportionate impact in low- and middle-income countries. Through DETECT-Asia, we are supporting new diagnostic capabilities that will save lives today while also building regional capacity for tomorrow. This programme directly supports our international mission to combat AMR and improve global health outcomes, and we look forward to working with Temasek Foundation, NUS Medicine, and other partners to strengthen infectious disease research and innovation across Asia.”
Dr Lee Fook Kay, Head, Pandemic Preparedness, Temasek Foundation, added, “At Temasek Foundation, we are committed to advancing healthcare innovation and resilience across Asia. With the Novo Nordisk Foundation and NUS Medicine, we seek to build up and link our hospitals to get faster and better data and testing by sharing through DETECT-Asia. This can help save lives, boost preparedness for future outbreaks, and scale innovations from the laboratories into standard care everywhere.”
The initiative advances global priorities in AMR and pandemic preparedness, while strengthening Asia’s leadership in infectious disease diagnostics and research.
- Advertisement -